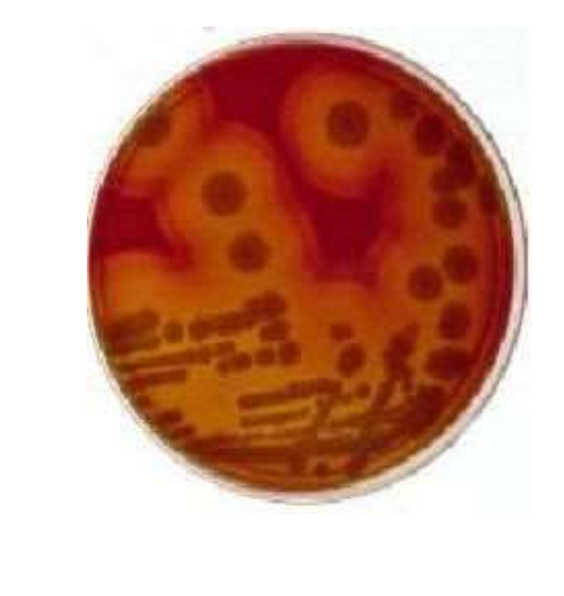

What does the genus Staphylococcuslook like on a gram stain?
gram positive, clustering cocci
Compare the shapes of Staphylococcusvs. Micrococcus.
Staphylococcus is spherical, Micrococcus is not always spherical
Compare the gram reactions of Staphylococcusvs. Micrococcus.
Staphylococcus is gram positive, Micrococcus decolorizes readily
Compare the colony colors of Staphylococcusvs. Micrococcus.
Staphylococcus has white to golden colonies, Micrococcus has clear to yellow colonies
Compare the hemolysis patterns of Staphylococcusvs. Micrococcus.
Staphylococcus has some hemolytic species, Micrococcus is nonhemolytic
Compare the O2 requirements of Staphylococcusvs. Micrococcus.
Staphylococcus is faculative, Micrococcus is an obligate aerobe
Compare the salt tolerance of Staphylococcusvs. Micrococcus.
Staphylococcus has good salt tolerance, Micrococcus has poor salt tolerance
What inactivates lipases?
there is a prophage that has inserted into the lipase gene and inactivates it
What is alpha hemolysis?
the incomplete lysis of RBC’s
What is beta hemolysis?
the complete lysis of RBC’s
What is gamma hemolysis? And do we care?
no hemolysis - no we use the term ‘no hemolysis’
What type of hemolysin causes alpha hemolysis?
beta
What type of hemolysin causes beta hemolysis?
alpha
If both hemolysin are present, then what pattern of hemolysis occurs?
double zone hemolysis
What is shown here?
double zone hemolysis
What is the structure of staphylococcal alpha hemolysin?
it assembles as a mushroom shaped heptamer with a central channel
What does staphylococcal alpha hemolysin do?
it forms poers in cell membranes and produces a lot of tissue necrosis
What is the function of beta hemolysin?
it has phospholipase C activity - it causes the collapse of the erythrocyte cell membrane
T/F: Gamma hemolysin is only one protein.
False - it is made up of three proteins; A, B, and C
What properties does gamma hemolysin have?
inflammatory properties
What type of hemolysis does delta hemolysin have?
complete
What type of action does delta hemolysin have?
detergent-like action
What is the function of leukocidin and what is it active against?
it kills white cells - only active against neutrophils and macrophages
What are PNAGs?
poly-N-acetylglucosamines - extracellular polysaccharides mediating biofilm formation


